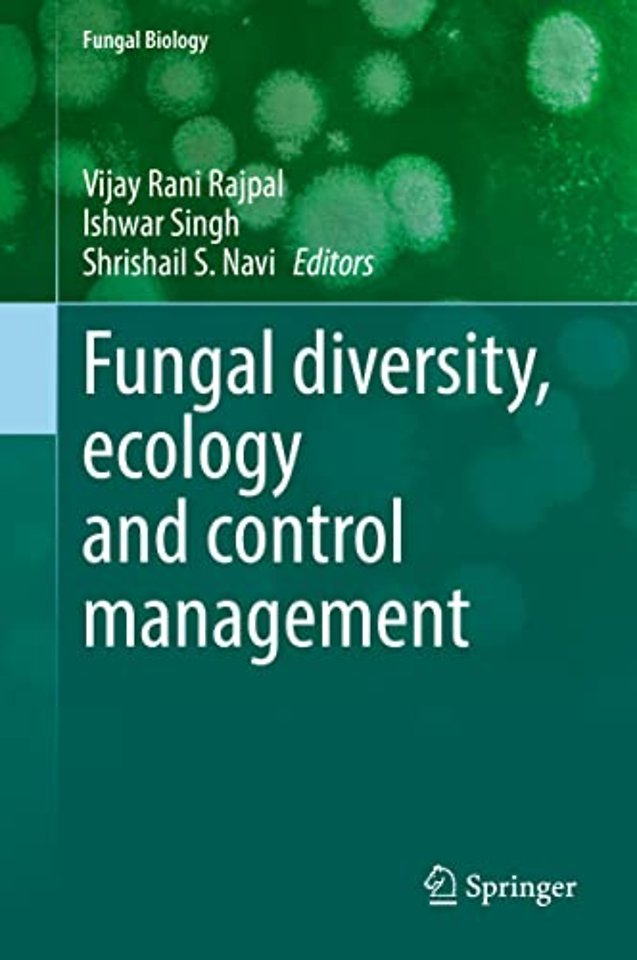

Fungal diversity, ecology and control management
Samenvatting
This edited volume provides comprehensive and latest information on the fungal biodiversity in its morphological characters, bioactive molecules, pathogenicity and virulence, and its impacts on crop production and sustainable management of agricultural productivity towards resolving global food security issues. The increasing number of infectious fungal diseases are regarded as threats to agricultural productivity and global food security. The efforts done by scientists to inventories the fungal diversity and identification of fungal species contributing as pathogens towards many plant and human diseases have been compiled in the present volume. The identification of the potential fungal pathogens is a prerequisite for an effective disease control management program. Also important is to understand the complex interactions between the host-pathogen and the environment. The book dwells on insights on the aforementioned aspects. The book also includes articles onecological significance of fungi and fungal antagonists used as biocontrol agents on other pathogens. This compilation is useful to scientists working in similar areas as well as to undergraduate and graduate students keen on getting updated information on the subject. Scientists involved in agricultural research, crop management, and industries that manufacture agrochemicals may also find it useful read.